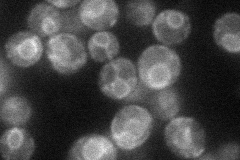

View description
Member of the cation diffusion facilitator family, localizes to the endoplasmic reticulum and nucleus; mutations affect the cellular distribution of zinc and also confer defects in meiotic recombination between homologous chromatids
Localization:
Intensity:
Fold change:
Significance:
-
C’ GFP library in SD

ER27.45 -
N' NOP1pr-GFP in SD
ER40.4628 -
N' TEF2pr-mCherry in SD

ER21.0581 -
N' NATIVEpr-GFP in SD

ER23.9809 -
N' TEF2pr-VC and Cyto-VN in SD

below threshold28.121 -
C’ GFP library in SD+DTT

ER29.561.07No -
C’ GFP library in SD+H2O2

ER28.391.03No -
C’ GFP library in Starvation Media

ER27.951.01No -
C’ GFP library on the background of Pup2-DaMP

ER -
C’ GFP library on the background of CCT mutant

ER23.51840.856316No
